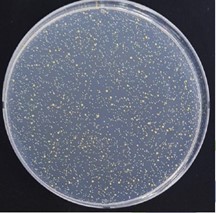

私たちが日常に手で触れることの多いプラスチック成形品には、さまざまな抗菌加工技術が紹介されています。
ところで、「抗菌」とはどんな働きをする機能なのでしょうか?普段よく耳にする言葉ですが、ちゃんと説明できる人は案外少ないかもしれません。
この記事では、抗菌という言葉の定義、その機能の評価方法を解説し、最後にNISSHAが提供する抗菌機能付き加飾成形品を紹介します。

抗菌とは|菌等の抑制に関する用語の定義
菌等を抑制する機能を表現する言葉には「抗菌」「殺菌」「除菌」などさまざまな言葉があります。これらはすべて異なる機能を表しており、言葉の意味が明確に定義されています。
-
- 抗菌
- 製品の表面における細菌の増殖を抑制すること。
菌の繁殖を抑える性質のある物質を製品の表面にコーティングしたり、製品そのものに抗菌剤を配合することで、製品表面で細菌が増えるのを防ぐ機能です。
-
- 除菌
- ある物質または限られた空間から微生物を除去すること。洗剤などで細菌を洗い流したり、フィルター濾過により菌を取り除くことが除菌にあたります。
-
- 滅菌
- 微生物を完全に死滅させること。火や蒸気、オーブンなどで加熱したり、放射線を照射するなどして、製品表面に付着した細菌を完全に死滅、除去することを指します。
-
- 殺菌
- 細菌などの微生物を死滅させること。「滅菌」が細菌を完全に死滅させることを意味するのに対して、「殺菌」という言葉では細菌をどの程度死滅させるのかは定義されていません。処理の方法としては、滅菌と同じく加熱や放射線照射など、またオゾンによる燻蒸殺菌なども使われています。
-
- 消毒
- 微生物のうち病原性のあるのもをすべて殺滅・除去してしまうこと。消毒は「病原性のある」微生物に対する処理なので、全ての細菌を殺滅・除去するものではありません。加熱消毒や、エタノールなどでの洗浄消毒がよく知られています。
これら用語のうち「殺菌」「滅菌」「消毒」は薬機法対象製品(医薬品・医薬部外品・化粧品・医療機器)でしか使用することができません。
また、同じ微生物でも細菌とウィルスは全く違う存在です。(そもそもウィルスが生物か無生物かというのは非常に難しい問題です)「抗菌」と「抗ウィルス」は全く違う機能なので注意が必要です。
抗菌性能の評価方法
プラスチック製品、金属製品、セラミック製品などの抗菌性能を付与した製品では、JIS Z 2801(ISO22196)「抗菌加工製品-抗菌性試験方法・抗菌効果」という規格により評価基準が定められています。これは国際的な基準となっています。 JIS Z 2801では、次のように抗菌性能を評価します。
試験の手順(出典:JIS Z 2801 5.6 試験操作)
- シャーレ内の試験片(5cm×5cm)に試験菌液0.4mlを滴下し、フィルム(4cm×4cm)をかぶせ、シャーレのふたをする。
- シャーレを35±1℃,90%RH以上で24±1時間培養する。
- フィルムと試験片をストマッカー袋に入れてSCDLP培地10mlを加え、試験菌を洗い出す。
- 洗い出し液中の菌数を寒天平板培養法により測定し、抗菌活性値を算出する。
抗菌機能の評価方法(出典:JIS Z 2801 5.8 試験結果)
抗菌性能は「抗菌活性値」という数値を算出して評価します。抗菌活性値は次の計算式で算出されます。
抗菌活性値 = log(非抗菌加工試料1cm2当たり・培養後生菌数) – log(抗菌加工試料1cm2当たり・培養後生菌数)
抗菌活性値 ≧ 2.0で抗菌効果が認められます。
これは、抗菌加工試料の生菌数が無加工試料の生菌数の1%以下となることを意味します。
抗菌機能付与にも対応するNISSHA の加飾成形技術
NISSHAはデザイン性の高いプラスチック製品を製造する加飾同時成型技術IMD/IMLを提供しています。IMD/IMLでは、絵柄やロゴなどの意匠パターンを印刷したフィルム(または転写箔)を製品の表面にインサートします。
このフィルムや転写箔の表面には抗菌コート層を設けることが可能です。透明性に優れた抗菌コート層はデザイン性を損なうことなく、プラスチック製品の表面を衛生的に保ちます。
NISSHAで抗菌コートしたプラスチック成形品をJIS Z 2801に基づく方法で試験した結果、抗菌性能を表す抗菌活性値は5.3となり、高い抗菌性能を確認しています。
| 非抗菌加工品 | NISSHA抗菌加工品 | ||
|---|---|---|---|
| 大腸菌 | 24h培養後生菌 | ![]() |
![]() |
| 抗菌活性値 | – | 5.3 | |
| 黄色ブドウ球菌 | 24h培養後生菌 | ![]() |
![]() |
| 抗菌活性値 | – | 5.3 | |
NISSHAでは、抗菌機能と同時にハードコート性や耐薬品性などの耐久性も兼ね備えた加飾成形品を提供することが可能です。抗菌機能付きの加飾成形品についてはNISSHAのwebサイトでより詳しく紹介しています。是非、ご覧ください。
詳しくはこちら
関連記事
(FilmDeviceコラム) タッチパネルは接触から非接触へ―タッチレス操作の非接触タッチパネルとは